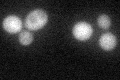
YHR046C
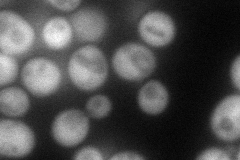
YHR046C
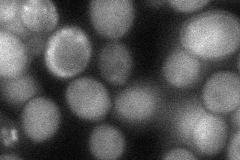
YHR046C
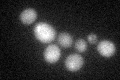
YHR046C

View description
Inositol monophosphatase, involved in biosynthesis of inositol and in phosphoinositide second messenger signaling; INM1 expression increases in the presence of inositol and decreases upon exposure to antibipolar drugs lithium and valproate
Localization:
Intensity:
Fold change:
Significance:
-
C’ GFP library in SD
cytosol33.79 -
N' NOP1pr-GFP in SD
cytosol87.2291 -
N' TEF2pr-mCherry in SD

missing0 -
N' NATIVEpr-GFP in SD

below threshold17.0836 -
N' TEF2pr-VC and Cyto-VN in SD
cytosol56.4361 -
C’ GFP library in SD+DTT
cytosol26.70.78No -
C’ GFP library in SD+H2O2

cytosol35.71.05No -
C’ GFP library in Starvation Media

cytosol16.480.48No -
C’ GFP library on the background of Pup2-DaMP

cytosol -
C’ GFP library on the background of CCT mutant

cytosol37.20941.10077No
